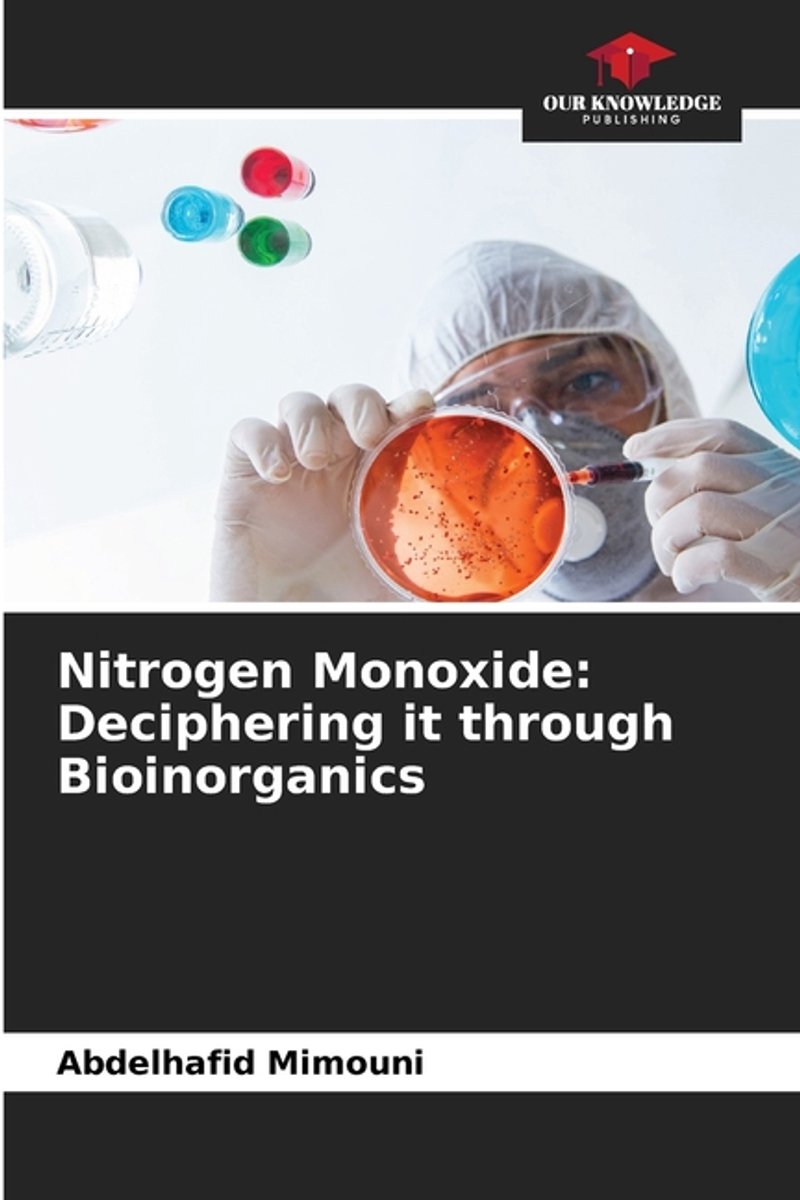

We hebben 52 boeken gevonden van de auteur Abdelhafid Mimouni
Hieronder vindt u een lijst met alle gevonden boeken van de auteur Abdelhafid Mimouni.
De meest gevonden boeken zijn Metal Links In Als, Gout And Antioxidants, Xas, Hexaaminecobalt Decoded By Xanes And Feff en Metalloproteins Deciphered By Xanes Spectroscopy.
De meest gevonden boeken zijn Metal Links In Als, Gout And Antioxidants, Xas, Hexaaminecobalt Decoded By Xanes And Feff en Metalloproteins Deciphered By Xanes Spectroscopy.
Sorteer op: